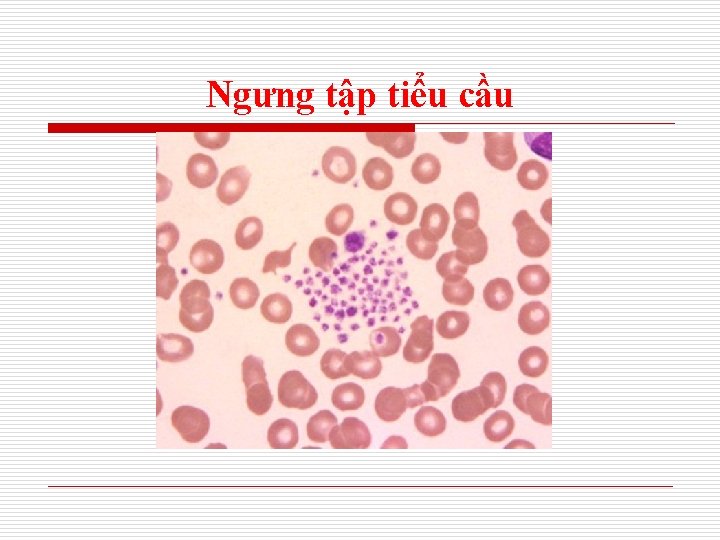
Ngưng tập tiểu cầu
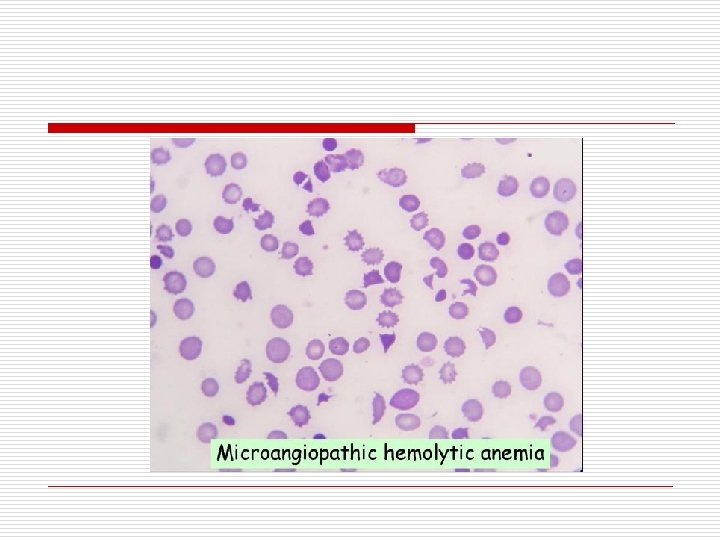
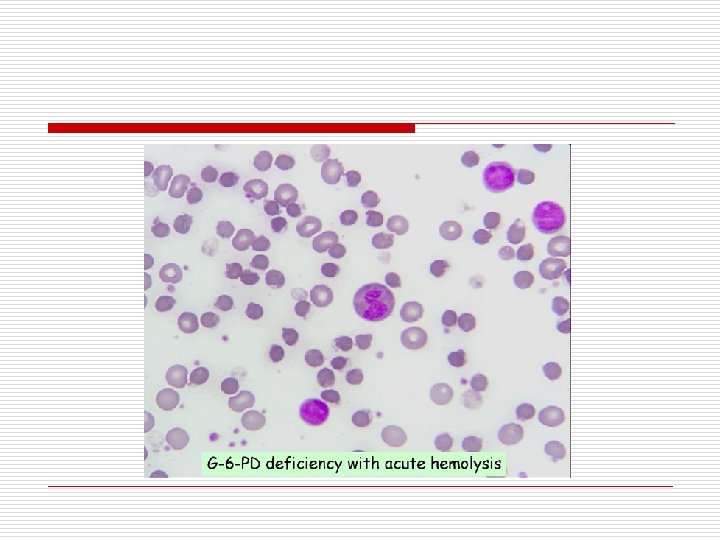
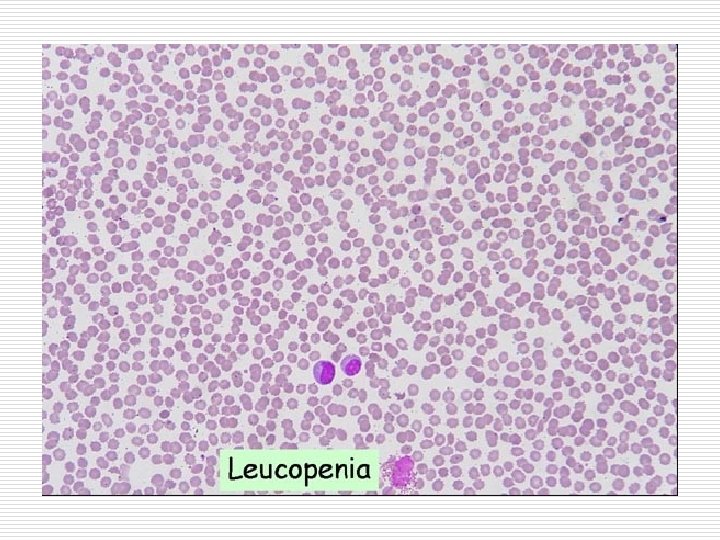
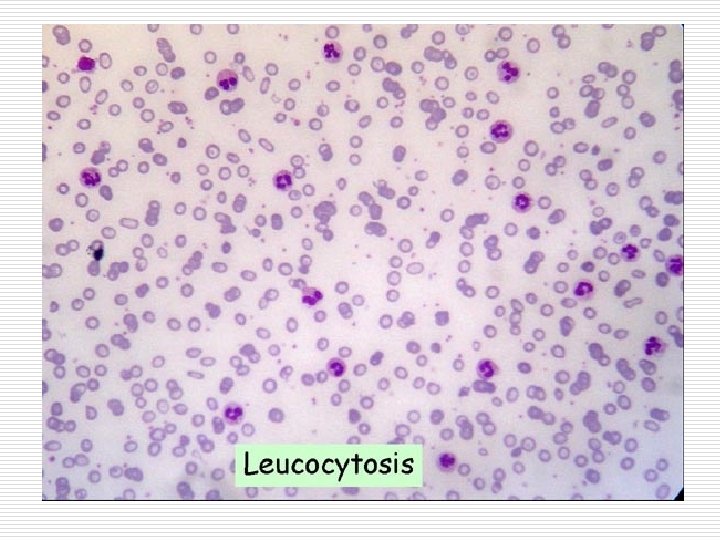
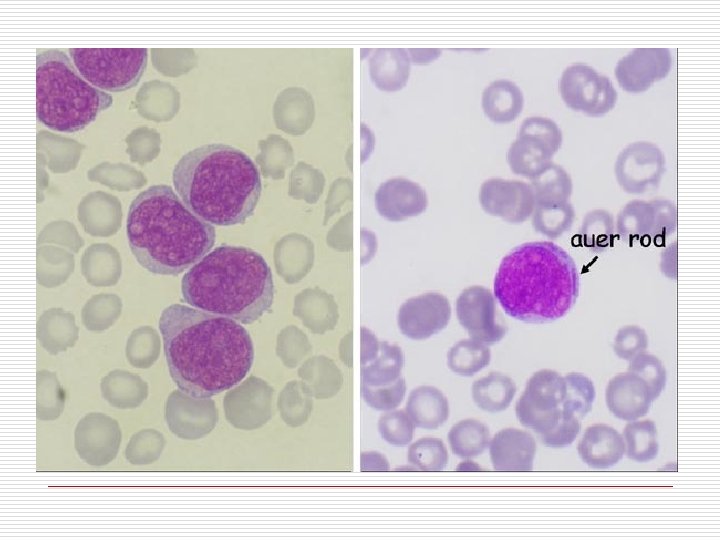
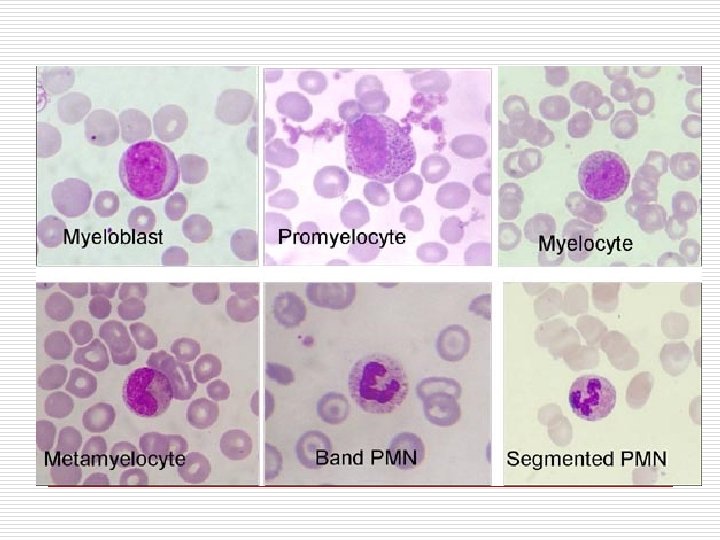

CNG THC MU Th BS Suzanne MCB Thanh

CÔNG THỨC MÁU Th. BS. Suzanne MCB Thanh

I. CÔNG THỨC MÁU BÌNH THƯỜNG. 1. HC (RBC ) : 3. 8 – 5. 9 T/L Hb : 12 -17 g % Hct : 38 - 50 % MCV : 80 -100 f. L MCH : 27 -32 pg MCHC : 32 -36 g % RDW : 11 -14 %

I. CÔNG THỨC MÁU BÌNH THƯỜNG. o o 2. BC (WBC ) : 5 -11 G /L (5000 - 11000 /mm 3) N : 45 -70 % : 1. 8 – 7 G/L (1800 - 7000 / mm 3) L : 20 -40 % : 1 – 4. 8 G/L (1000 - 4800/ mm 3) M: 1 -2, 5% : 0 - 0. 8 (0 - 800/ mm 3) E: 1 -3 % : 0 - 0. 45 (0 - 450/ mm 3) 3. TC (PLT) : 150 - 300 G/L : 150. 000 -300. 000 / mm 3

Hoàng caàu vaø baïch caàu

Hồng cầu và Tiểu cầu

II. CÁC KÝ HIỆU TRONG CÔNG THỨC MÁU 1. RBC : Red Blood Cell ANISO : Anisocytosis : HC đa kích thước POIKILO: Poikilocytosis : HC đa hình dạng HYPER : Hyperchrome : HC ưu sắc Macro : Macrocyte : HC to Micro : Mycrocyte : HC nhỏ NRBC : Nucleated Red Blood cell : HC nhân HC Var : Hb concentration Variance: Sự biến thiên của nồng độ Hb. RBC Fragment: Mảnh vỡ hồng cầu. RBC Ghost : HC hư o

II. CÁC KÝ HIỆU TRONG CÔNG THỨC MÁU (tt) o 2. WBC: White Blood Cell: Bạch cầu. Atyp: Atypical lymphocyte: Tế bào lympho không điển hình. LUC: Large Unstained Cell: tế bào lớn không bắt màu. Ig: Immature Granulocyte: Bạch cầu chưa trưởng thành. Band: Bạch cầu gậy. MN: Mononuclear : BC đơn nhân. PMN: Polymorphonuclear : BC đa nhân. Retic: Reticulocyte: HC lưới. LS: Left shift: BC chuyển trái. Blast: BC non.

II. CÁC KÝ HIỆU TRONG CÔNG THỨC MÁU (tt) o 3. PLT : platelet : tiểu cầu Large PLT : Platelet with volume greater than 20 f. L : TC lớn MPC : Mean of Platelet PC histogram PLT clumps : TC bị vón cục
Ngưng tập tiểu cầu

III. GIẢM BC HẠT (Neutrophile giảm ) o o -Số lượng BC hạt < 1800 / mm 3 -Nguy cơ nhiễm trùng sẽ rất cao , nhất là khi BC hạt <500/ mm 3.

III. GIẢM BC HẠT (Neutrophile giảm )(tt) o Nguyên nhân : 1. Do thuốc : là nguyên nhân thường gặp nhất. VD : Indomethacine, Acetaminophene, Phenylbutazol, Chloramphenicol Carbimazole, Propylthiouracil, Chlorpromazine 2. Tổn thương tủy: Suy tủy thật sự Bạch cầu cấp, Rối loạn sinh tủy. 3. Dinh dưỡng Thiếu Vitamine B 12, acide folic, Thiếu đồng , Chán ăn.

III. GIẢM BC HẠT (Neutrophile giảm )(tt) 4. Giãm BC do tự miễn: có kháng thể kháng BC - Lupus (50% cas có giảm BC , 75 % có thiếu máu, 20 % có giảm Tiểu cầu ) - Viêm khớp dạng thấp : 3% Bn có giảm BC - HC Felty (Viêm khớp , lách to , giảm BC ). 3/4 cas cắt lách thì BC tăng - Hodgkin , Viêm gan tự miễn , bệnh Crohn. 5. Nhiễm trùng - Vi trùng : Gr (- ), lao, thương hàn - Virus : HIV , HBV, siêu vi hô hấp - Ký sinh trùng sốt rét. - Rickettsia.

III. GIẢM BC HẠT (Neutrophile giảm )(tt) 6. Giảm BC hạt chu kỳ o Mỗi chu kỳ là 21 ngày, mỗi đợt là 3 -6 ngày: Sốt , loét họng , hạch to, thường xảy ra ở trẻ em. 1/3 cas có di truyền trên nst thường, là do khiếm khuyết về quá trình tạo máu. Điều trị bằng G- CSF. 7. Giảm BC bẩm sinh o HC Kostman: di truyền trên nst lặn : viêm tai , viêm nướu , nhiễm trùng huyết lúc sơ sinh. BC hạt <200. Điều trị : G-CSF , ghép tủy.

IV. TĂNG BC HẠT Khi số lượng tuyệt đối >7500 / mm 3 o - Cơ chế 1 - Tăng sản xuất tế bào. 2 - Tăng phóng thích tế bào ra máu ngọai biên. 3 - Tăng vận chuyển tế bào từ những nơi chứa máu ở ngoại biên vào hệ tuần hoàn (hiếm khi tăng hơn gấp 2 lần). 4 - Giảm BC đi vào mô. 5 - Kết hợp nhiều cơ chế trên. o -Thời gian đòi hỏi tăng BC - Vài phút : từ những nơi chứa máu ở ngoại biên. - Vài giờ: tăng phóng thích từ tủy xương. - Vài ngày : tăng sản xuất tế bào.

IV. TĂNG BC HẠT (tt) Nguyên nhân 1. Cấp o Họat động thể lực , co giật , gây mê , lạnh , nóng , sanh , mổ , đau. o Xúc động : lo lắng , sợ hải , stress nặng o Nhiễm trùng o Mô viêm , họai tử o Thuốc: Epinephrine , G-CSF, hormone , độc tố , thuốc lá 2 gói / ngày.

IV. TĂNG BC HẠT (tt) 2. Mãn - Nhiễm trùng : Nhất là Gr (-) - Viêm : viêm mạch máu , viêm đại tràng, viêm da, phản ứng thuốc, gout. - Viêm thận, viêm tụy - Ung thư : vú, thận , gan , phổi , tụy, Hodgkin , lymphoma , đa u tủy. - Dùng corticoide , tăng tiết ATCH. - Bệnh về máu : tán huyết , giảm tiểu cầu, tăng sinh tủy - HC Down

V. Tăng Eosinophile o o o Số lượng tuyệt đối > 400 mm 3 Nhẹ > 400 - 1500 / mm 3. Trung bình > 1500 - 5000 mm 3 Nặng > 5000 mm 3 Nguyên nhân : . Ký sinh trùng. Suyển. . Dị ứng : thuốc. . Viêm da dị ứng , viêm mũi. Dị ứng thường gây tăng BC ái toan nhẹ

VI. Tăng basophile máu o Bình thường : 20 -80 / mm 3 Tăng >100 / mm 3 o -Nguyên nhân : o Dị ứng thuốc, viêm Tiểu đường , dùng estrogen Cúm , lao Thiếu sắt HC tăng sinh tủy, CML, đa HC , tăng TC nguyên phát Carcinome BC cấp dòng basophile

VII. Tăng Monocyte (Tăng monocyte >800/ mm 3. ) Nguyên nhân o Bệnh về máu : rối lọan sinh tủy, BC cấp , BC mãn dòng tủy, Lymphoma , Hodgkin , đa u tủy, sau cắt lách. o Collagene Viêm đa khớp dạng thấp Lupus Viêm nút quanh động mạch Viêm động mạch thái dương

VII. Tăng Monocyte (Tăng monocyte >800/ mm. ) 3 o o Nhiễm trùng Viêm mãn : Viêm nội tâm mạc bán cấp do vi trùng , viêm amygdale, nhiễm trùng răng , abces gan, lao , giang mai Virus : CMV, Varicella zoster Những trường hợp khác Tiêu chảy Viêm đại tràng mãn Viêm hạch vùng Sarcoidosis Viêm gan do rượu Ngộ độc tetrachloroethane Bệnh mô bào Langerhans Trầm cảm nặng

VI. Tăng lymphocyte >4000/ mm 3 Nguyên nhân o Tăng lympho nguyên phát Tăng lympho ác tính : ALL, CLL, lymphoma o Tăng Lympho phản ứng Hội chứng tăng BC đơn nhân: do Epstein –Barr virus (EBV), Cytomegalo virus (CMV), toxoplasma gondi, HIV, herpes simplex virus , Varicella virus , rubella virus , adeno virus , virus viêm gan, Bordetella pertussis

Tăng lymphocyte (tt) Tăng lymphocyte >4000/ mm 3 o o Stress: Trụy tim mạch : NMCT, suy tim Choáng Thuốc Phẫu thuật Chấn thương Tăng lympho mãn Ung thư Rối lọan miễn dịch Hút thuốc lá Viêm amygdale mãn Cắt lách Sarcoidosis Bướu tuyến ức

Giảm lymphocyte. Khi <1000/ mm o 3 Thường giảm CD 4 (T cell Helper ) (Bình thường máu ngọai biên 80 % là lympho T , 2/3 là CD 4 ) Nguyên nhân : o o -Di truyền : suy giảm miễn dịch bẩm sinh. -Mắc phải: . Suy tủy. Nhiễm virus : AIDS , viêm gan, cúm , . Nhiễm trùng : Lao, thương hàn , viêm phổi. . Thuốc : ức chế miển dịch, globulin antilymphocyte, . Glucocoticoide, hóa trị , xạ trị , phẩu trị, . Dẫn lưu ống ngực. Bệnh tự miễn. Thiếu kẽm , suy dinh dưỡng nghiện rượu. HIV phá hũy CD 4 T Cell (<300 CD 4 T cell)

o o HỒNG CẦU NHỎ NHƯỢC SẮC : -Thiếu sắt -rối loạn sử dụng sắt -Thalassemie

Hồng cầu to ưu sắc o o o -Thiếu Vitamine B 12 - Thiếu Acide folic -tán huyết (HC nhân ra máu ngoại biên )

- Slides: 37